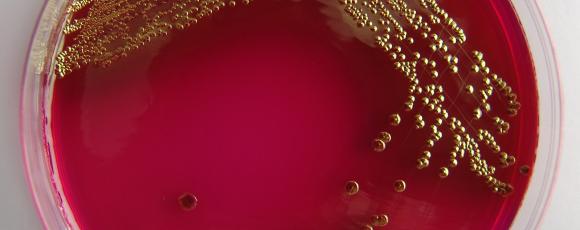

Články
Související články
S novým překvapivým objevem přišli výzkumníci z univerzity v Calgary v Kanadě. Navrhli speciální…
Přehledový článek uveřejněný v jednom z loňských vydání odborného časopisu Advances in Skin &…
Řezné a bodné rány patří mezi závažná poranění, u kterých hrozí riziko poškozený hlubokých struktur…
4. a 5. října 2012 proběhl v Hradci Králové již 17. ročník konference Společnosti popáleninové…
Normální zdravá kůže plní mnoho funkcí. Hlavní z nich je ochrana těla před chemickými, fyzikálními…
Tým výzkumníků z newyorské státní University v Binghamtonu se domnívá, že pochopení komunikace mezi…
Studie uveřejněná v mezinárodním odborném časopise PLOS Medicine a komentovaná na serveru www.…
Standardní léčba bércových vředů za použití vhodného krytí a komprese bývá úspěšná ve 30 až 75 %…
Diabetické vředy jsou častou komplikací cukrovky a příčinou více než 80 % amputací dolních končetin…